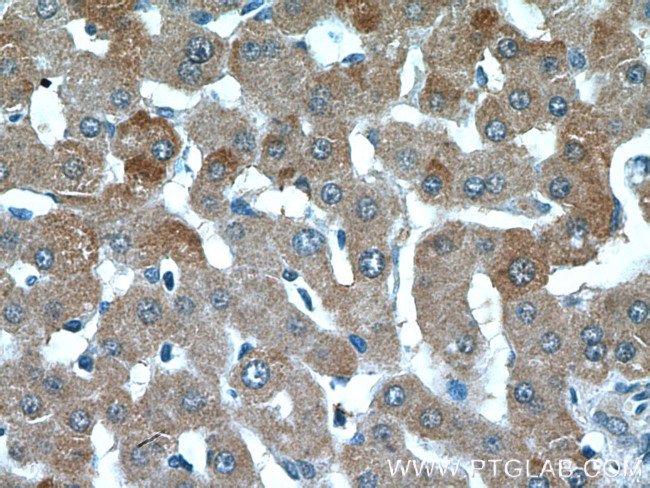
C1R Antibody in Immunohistochemistry (Paraffin) (IHC (P))

Search
Proteintech
C1R Polyclonal Antibody
{{$productOrderCtrl.translations['antibody.pdp.commerceCard.promotion.promotions']}}
{{$productOrderCtrl.translations['antibody.pdp.commerceCard.promotion.viewpromo']}}
{{$productOrderCtrl.translations['antibody.pdp.commerceCard.promotion.promocode']}}: {{promo.promoCode}} {{promo.promoTitle}} {{promo.promoDescription}}. {{$productOrderCtrl.translations['antibody.pdp.commerceCard.promotion.learnmore']}}
产品信息
17346-1-AP
种属反应
宿主/亚型
分类
类型
抗原
偶联物
形式
浓度
规格
纯化类型
保存液
内含物
保存条件
运输条件
产品详细信息
This antibody recognizes full-length C1r chain and the cleaved B chain.
Immunogen sequence: AVCQDDGTW HRAMPRCKIK DCGQPRNLPN GDFRYTTTMG VNTYKARIQY YCHEPYYKMQ TRAGSRESEQ GVYTCTAQGI WKNEQKGEKI PRCLPVCGKP VNPVEQRQRI IGGQKAKMGN FPWQVFTNIH GRGGGALLGD RWILTAAHTL YPKEHEAQSN ASLDVFLGHT NVEELMKLGN HPIRRVSVHP DYRQDESYNF EGDIALLELE NSVTLGPNLL PICLPDNDTF YDLGLMGYVS GFGVMEEKIA HDLRFVRLPV ANPQACENWL RGKNRMDVFS QNMFCAGHPS LKQDACQGDS GGVFAVRDPN TDRWVATGIV SWGIGCSRGY GFYTKVLNYV DWIKKEMEEE D (356-705 aa encoded by BC035220)
靶标信息
C1 component of human complement is a complex of three glycoproteins: C1q, C1r and C1s. C1r has a molecular weight of 83,000 and is present in plasma in an average concentration of 50 µg/mL, either as a complex with C1q and C1s or in the absence of C1q as a tetramer with C1s. The subcomponents of the C1 complex are responsible for the initiation of the classical pathway of complement activation.
仅用于科研。不用于诊断过程。未经明确授权不得转售。
生物信息学
蛋白别名: Complement C1r subcomponent; Complement component 1 subcomponent r; complement component 1, r subcomponent; human complement C1r; unnamed protein product
基因别名: C1R; EDS8; EDSPD1
UniProt ID: (Human) P00736
Entrez Gene ID: (Human) 715